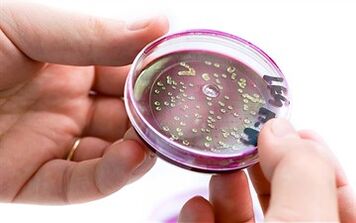
Bacteria in prostate secretions

For many years, prostatitis in men has been considered a very common pathological process that disrupts the functioning of the glandular organ.
The prostate itself will perform three main functions - motor, secretory and barrier.After all, the secretion released by this glandular organ is rich in amino acids, vitamins, special enzymes and zinc.
Over time, serious disorders of sexual function and a decrease in the quality of life are observed.In order to avoid negative consequences, urologists recommend the use of complex drug treatment for prostatitis.Only in this case can we hope for a full recovery and normalization of the genitourinary system.
Forms of prostatitis in men and their symptoms

Practicing urologists consider this disease to be the most common and dangerous disease that most often affects elderly men.
Often, representatives of the stronger sex simply hide existing health problems.
This behavior is extremely dangerous, as it can provoke complications, including cancer.That is why it is necessary to know the forms of prostatitis and their characteristic symptoms.
Spicy

This form of pathology is characterized by the fact that there is acute inflammation in the patient's body, which is provoked by pathogenic microorganisms.
Most often, the main cause is the rapid proliferation of E. coli, and in some cases the main pathogen can be ordinary amoeba or enterococci.
It is worth noting that many of these representatives of the microflora are constantly in the human body, but in some cases, against the background of weakened immunity, their uncontrolled growth may occur.Acute prostatitis is characterized by rapid development and certain symptoms.

The patient can independently determine his condition if he experiences the following symptoms:
- erectile dysfunction;
- unreasonable feeling of severe malaise;
- periodic discharge of pus from the urethra;
- frequent urge to urinate;
- sharp pain that can affect the anal area, perineum, lower back, radiating to the lower limbs.
Chronic
The chronic type of prostatitis differs in that, if you do not undergo timely treatment, the pathology can develop into a more dangerous and complex form - an adenoma.
The disease is dangerous because it develops quite slowly and the symptoms are mild.This disease can be caused by microorganisms that manage to penetrate the glandular organ.
But in rare cases, the disease develops due to chronic stagnation and age-related changes.Urologists note that in medical practice there are situations when, after complete recovery from infectious microorganisms, the prostate is attacked by its own immune system.
Most often, this happens against the background of the fact that the patient's body has been systematically exposed to various adverse factors.

The following symptoms are characteristic of chronic prostatitis:
- general weakness in the whole body;
- periodic pain in the perineum, which can also be accompanied by various unpleasant sensations;
- weakening or complete suppression of sexual desire for the opposite sex;
- itching, burning and even pain in the groin area.
Only a specialist who will conduct all the necessary laboratory tests and palpation of the organ can make a correct diagnosis.
bacterial
It can have an acute or chronic form.The main provocateur of the disease is considered to be a certain group of bacteria.
All symptoms are characteristic of acute damage to the glandular organ.Laboratory studies allow you to detect existing inflammatory foci in the secretion.
Characteristic signs of the bacterial form of the disease are:
- violation of the biological function of the genitourinary system (frequent urges to urinate, impaired erectile function and inability to completely empty the bladder);
- general inflammation;
- specific changes in the composition of biological fluids.
The diagnosis is made only after an examination.The bacterial type of prostatitis most often occurs in people of reproductive age (from 19 to 42 years).Its prevalence among the remaining group of men is quite low - only 10%.
Calculous

This form of prostatitis is characterized by inflammation of the glandular organ, which occurs against the background of the presence of specific stones.
This type of disease is considered quite rare, as it is mainly diagnosed in elderly men.
The stones themselves are formed from exudate, phosphates, prostatic secretions and calcifications.
The symptoms of the calculous form of prostatitis are as follows:
- pain in the sacrum and pelvis, which increases during intimacy, as well as when walking;
- small amounts of blood in the semen;
- urination disorder;
- increased irritability;
- erectile dysfunction;
- depression and apathy.
How to treat the prostate gland with drugs?

Each case must be considered individually by urologists.This is due to the fact that the etiology of prostatitis is different for each man, which is why high-quality therapy differs in its specific effects.
During the treatment period, the specialist can make any adjustments.
To improve efficiency and quick recovery, you can take certain herbal teas, as well as do regular massage.
But the main emphasis is on drugs, since they are the ones that can deal with pathogenic microorganisms and bacteria, preventing possible complications of the disease.
Drug treatment of prostatitis at home

Is it possible to take a course of drugs to combat inflammation of the glandular organ at home?This depends on the patient's condition.
In this case, the features of the prostate structure, the causes of the disease, whether the man is allergic to a certain group of drugs, as well as the severity of the disease are of great importance.The final decision should always be made by the urologist.
If the treatment of prostatitis is based on regular use of drugs and therapeutic exercises, then it is not necessary to stay in the hospital for this.Eventually, you can make an appointment for physical therapy on an outpatient basis at your local clinic.
antibiotics

When choosing this group of drugs, it is important to remember that there are a huge number of them, and they all help to destroy harmful microorganisms.
Broad-spectrum antibiotics work well against any pathogen, but those drugs that are originally designed for specific microorganisms are more effective for the prostate.
Antibiotics can be taken in the form of injections (the most effective option), tablets or rectal suppositories.
Pain relievers

The correct treatment of prostatitis consists not only in taking antibiotics and immunostimulating agents, because alleviating the painful symptoms of the disease is no less important.
There are pain-relieving injections to combat the inflammation of the glandular organ.
In addition, the doctor can prescribe pain-relieving suppositories.
Alpha blockers
Such drugs have been at the peak of popularity for several years, as they help to eliminate the unpleasant symptoms of dysuria.Basically, this group of drugs is needed to achieve a hypotensive and vasodilating effect, as well as to lower blood sugar levels.
Drug treatment can only be started if approved by a urologist.
Medicines that improve blood circulation
With any form of prostatitis, there is a violation of the natural blood circulation, which is fraught with congestion and complications.Therefore, for complex treatment, it is necessary to use drugs that improve blood flow.
Muscle relaxants
Drugs of this group have an effect similar to alpha-blockers, only in this case the entire effect is directed to the striated muscles.After completing the full course, patients note a decrease in the general pressure on the pelvic organs, as well as the elimination of pain.
Herbal medicines and vitamins

Most patients tend to choose medicines that contain exclusively natural ingredients.
After all, their effect is aimed at reducing inflammation, relieving pain, removing swelling of the glandular organ and restoring the normal outflow of physiological fluids.
The most commonly used remedies are pumpkin oil..Medicines based on the fruits of the creeping palm and sabal are no less popular.
About the endolymphatic method of prostate treatment
Long-term clinical and experimental studies of the state of the lymphatic system show its leading importance in inflammatory processes.
In this way, the endolymphatic administration of drugs allows to reduce the number of injections to 1 injection per day.
In addition, the dose of administered drugs is reduced by 70%.The complete recovery of the patient takes place without the use of antibiotics, which has a positive effect on the functioning of the entire organism.































